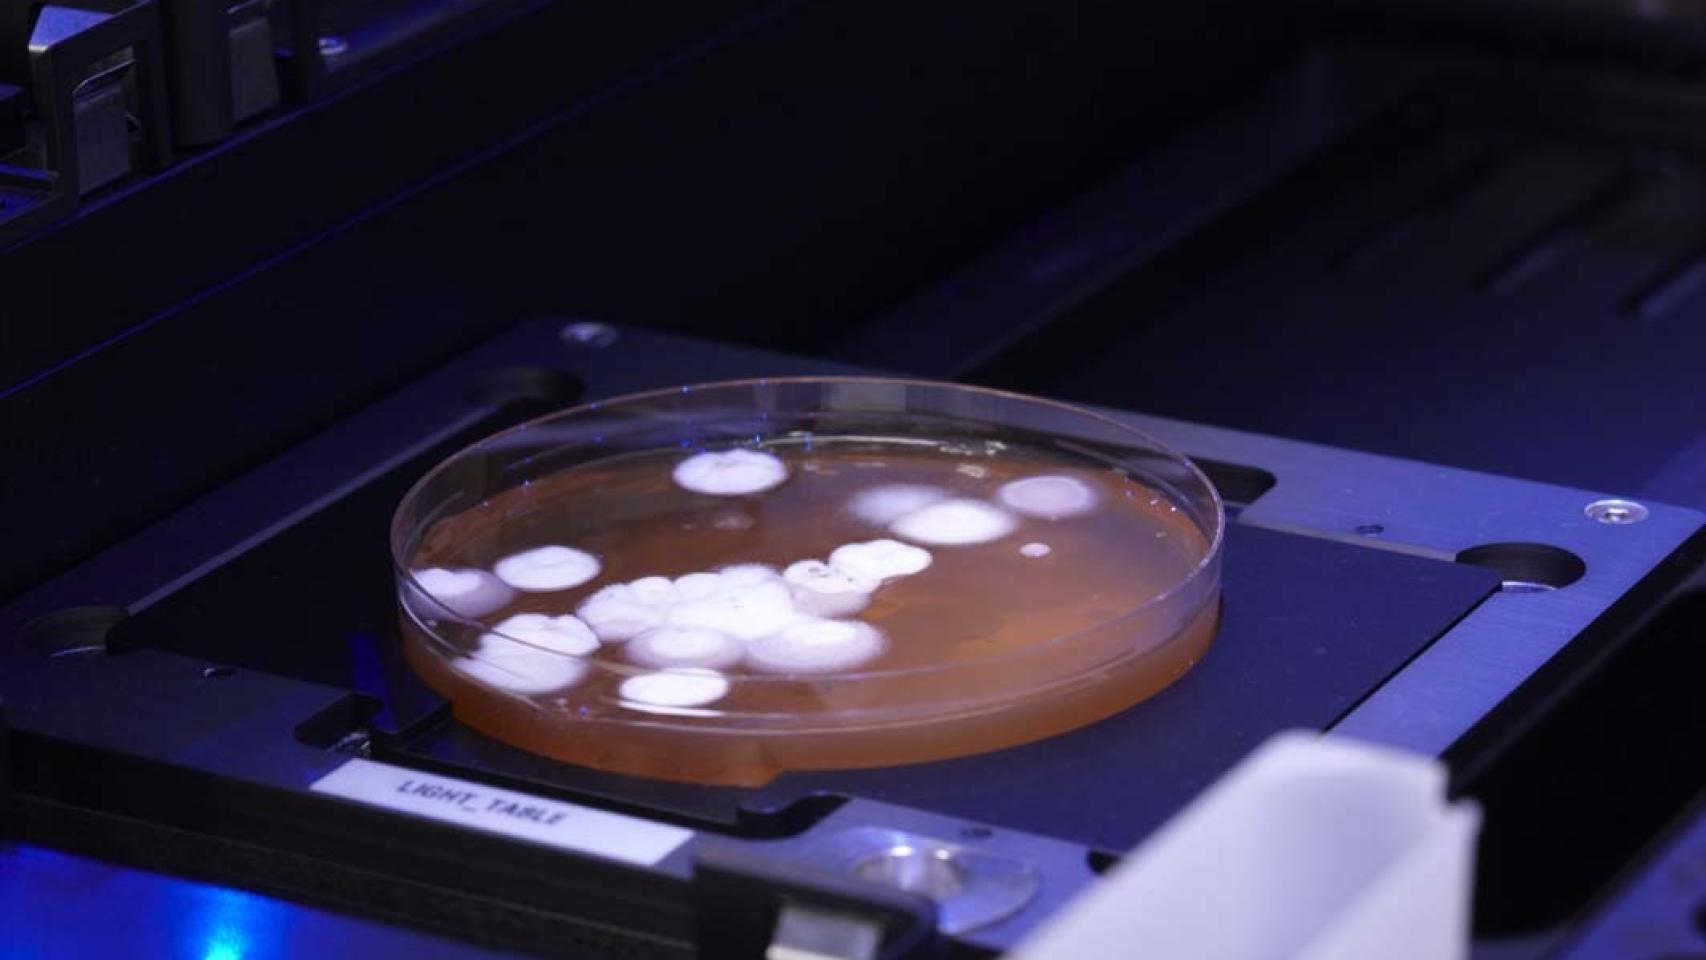
Uno de los cultivos de microorganismos en placa.

Laboratorio general.
Buscando un fármaco contra el alzhéimer desde cero
Seguimos todos los pasos en la investigación y desarrollo de nuevos medicamentos contra esta enfermedad neurodegenerativa en un laboratorio español.
Noticias relacionadas
Pocas enfermedades despliegan efectos tan terribles como los del alzhéimer. Sus procesos neurodegenerativos arrebatan, lenta pero inevitablemente, las capacidades mentales del paciente haciendo que desaparezca no sólo su salud sino su propia identidad, sus vivencias, sus recuerdos.
Lamentablemente, sabemos muy poco de este adversario. De hecho, si hoy intentásemos definir la enfermedad de Alzheimer, tendríamos que conformarnos con enumerar una larga serie de síntomas asociados. No obstante, definitivamente no podríamos decir cuál es su causa, sus mecanismos concretos de funcionamiento y, por supuesto, tendríamos que admitir que aún no poseemos ningún tratamiento efectivo que lo cure.
La búsqueda está abierta en todos los frentes. Para conocer cómo se enfrentan los científicos a todas estas incógnitas, visitamos las instalaciones de NeuronBio, una de las empresas españolas de biotecnología dedicadas a la investigación y producción de compuestos que ayuden a frenar el avance de enfermedades neurodegenerativas, en especial el alzhéimer. El objetivo es comprender todo el proceso, empezando por el principio.

Nuevas instalaciones de la empresa en el Parque Biotecnológico de Granada.
¿Por dónde empezar?
Es una mañana fría en el Parque Biotecnológico de Granada. Arropado con un gran abrigo y una bufanda, nos recibe Javier Burgos, doctor en Biología Molecular y director general de la empresa. Entramos en las instalaciones y nuestra primera parada es un gran armario cerrado bajo llave: "Esta es nuestra principal herramienta de trabajo". Tras las dos puertas que lo flanquean se esconde un ultracongelador que guarda celosamente una amplia colección de más de 9.000 microorganismos diferentes.
¿Cómo empieza una investigación tan ardua? Pues el primer paso es tener una buena selección de microorganismos. Se recogen en expediciones por todo el mundo: esponjas de fondos marinos, hongos extraídos en cuevas, bacterias encontradas en ríos... Desde las islas Seychelles o la Antártida hasta el Amazonas, pasando por simples microbios que puedes encontrar en cualquier jardín. En la actualidad, Neuronbio mantiene acuerdos con diversas instituciones que realizan expediciones extrayendo y catalogando muestras de todo tipo.
El objetivo final es descubrir qué moléculas son capaces de producir estos microorganismos y saber si pueden ser útiles para desarrollar un fármaco contra el Alzhéimer.
¿Casi como una especie de lotería? "En cierto modo sí... Aunque es una lotería orientada", responde el científico. "Imaginemos que buscamos una molécula que nos ayude a reducir el daño oxidativo de las células; entonces, nos vamos a ambientes extremos, como por ejemplo Río Tinto, donde existen microorganismos con mecanismos de defensa contra ese entorno tan oxidativo, los recogemos y trabajamos con ellos", añade.

Robot de cribado de alto rendimiento.
La siguiente estación del recorrido es un gran robot de cribado de alto rendimiento, una enorme máquina con capacidad para realizar docenas de cultivos simultáneos. Su diseño, montaje y adaptación a las necesidades específicas de cada centro requiere de muchos meses de trabajo.
"Es capaz de hacer 96 micro-fermentaciones a la vez", afirma Burgos. "Es decir, puedes hacer crecer una buena cantidad de microorganismos en una gran variedad de tipos de cultivos".
En esta sala los investigadores realizan cientos y cientos de cultivos, de los que muy pocos terminarán convirtiéndose en candidatos. "Nuestra quimera es encontrar una molécula que frene o incluso impida la muerte de las células neuronales", comenta, y puntualiza: "Podemos realizar hasta un millón de ensayos para encontrar una sola molécula candidata a fármaco".
Cada uno de esos 9.000 microorganismos se somete a una gran cantidad de pruebas que incluyen fermentaciones, agitaciones, tintes, mezclas... Por tanto, sí, es una especie de lotería, pero hay que considerar que históricamente toda esta etapa se realizaba manualmente. Hoy, el trabajo se han automatizado utilizando robots de este tipo.
Moléculas candidatas
En el proceso de descartar posibilidades, el próximo paso es la fermentación en matraz. Una vez que se ha encontrado una molécula candidata frente a una determinada diana, los investigadores pasan a someterla a más pruebas. Esta fase cada vez es más manual y arranca con los primeros controles de temperatura y agitación. La criba continuará con los tintes preseleccionados y se someten a nuevos controles más detallados: control del pH, de la temperatura, de la agitación de la pala... docenas de cables controlan el cultivo y los candidatos cada vez son menos.
Uno de los cultivos de microorganismos en placa.
En todo este camino, y mientras continúan los descartes y las cribas en los candidatos, el volumen del cultivo va aumentando. De unos pocos centímetros cúbicos va pasando a depósitos mayores de dos litros, luego de diez litros, hasta llegar a un gran tanque de 450 litros que se guarda en otra nave industrial anexa a las instalaciones.
Este crecimiento en volumen debe seguir estrictos controles en todos los parámetros para no perder la propiedad deseada. Es decir, si por ejemplo es un fármaco neuroprotector no puedes perder esa cualidad a lo largo de todo este camino.
Primeras pruebas en seres vivos
Después de todos estos escalones, se llega al primer rellano: el hallazgo de una molécula que podría ofrecer una utilidad terapéutica.
Para poder visualizar mejor todo el trayecto, Javier Burgos pone un ejemplo real: aprovechando que en Granada hay una buena producción de frutos tropicales, NeuronBio se propuso averiguar si los residuos de algunas de estas plantas tenían utilidad. Después de seguir todo este proceso descubrieron que ciertos residuos de plantas tropicales, como cáscaras de chirimoya o mango, ofrecían interesantes efectos frente al estrés oxidativo de las células.
¿Qué se hace con esa molécula candidata a fármaco? Los experimentos se trasladan ahora a otras instalaciones que albergan un gran animalario con más de 3.000 peces cebra (Danio rerio). Éstos son pequeños, se reproducen con rapidez, su mantenimiento es económico, su desarrollo embrionario transparente y su gran similitud genética con otros mamíferos, incluido el ser humano con quienes comparten el 86% de su material genético, convierten este pez en uno de los modelos más utilizados en biotecnología e investigación médica.

Instalaciones para peces cebra.
Las primeras cuestiones que surgen tras encontrar tu molécula maravillosa son relativas a su toxicidad, su seguridad y su eficacia. Para resolver estas dudas, el pez cebra ofrece un buen primer modelo de pruebas. La sala está repleta de pequeños tanques conectados. Bien organizados y etiquetados, cientos de estos peces se encuentran inmersos en diferentes pruebas.
"En esta habitación amanece y anochece", explica Javier Burgos, mientras señala el sistema automatizado que controla la luz, la temperatura y la humedad en toda la instalación. En uno de los rincones se conserva el tanque con los peces centinela que avisan con antelación si surge algún riesgo para el resto, ya que el sistema de agua está interconectada entre los tanques pero dividida en cuatro módulos.
Los peces cebra cuentan con un sistema de neurotransmisores muy similar al que posee cualquier mamífero, lo que le convierte en un modelo perfecto para hacer pruebas de toxicología y eficacia de nuestra molécula. De este modo se detecta si una molécula candidata a fármaco es segura, o de los contrario puede causar daños hepáticos, cardiacos, renales…
Laboratorio de punto final
El recorrido finaliza en un gran microscopio electrónico en el que una de las investigadoras muestra algunos de los embriones de pez cebra con los que están trabajando.

Embriones de pez cebra.
Un sistema muy preciso de microinyectores inocula la molécula seleccionada en embriones de pez cebra y, a partir de ese momento, es posible realizar infinidad de pruebas de seguridad. Entre otras, se realizan pruebas de toxicidad, es decir, se comprueba si la molécula candidata desarrolla efectos nocivos en el sistema auditivo del embrión.
Muy cerca de este área se encuentra el laboratorio de fenotipado-conductual, en donde se comprueba, además, si la molécula influye de alguna manera en el comportamiento del animal, en este caso, un pez.
¿Cómo se puede medir esto? Los investigadores de esta empresa cuentan con un modelo denominado Open Field, que observa el comportamiento del animal en una serie de laberintos. El más utilizado se denomina T-Maze (laberinto en forma de T), en el que un sistema de vídeo analiza todos los movimientos del animal: registra si se mueve, si se para o si nada de una forma extraña.
Si una persona se encuentra en una habitación desconocida y a oscuras, su comportamiento más frecuente es buscar una pared, seguirla e intentar deducir la estructura donde se encuentra. En estos peces ocurre algo similar, por lo que gracias al laberinto es posible comprobar si la molécula seleccionada comporta efectos negativos en su actividad, si produce ansiedad, miedo, estrés...
Si se acondiciona uno de los extremos del laberinto con vegetación o unas piedras, haciendo que esa parte sea más cómoda para el pez, se obtiene un entorno idóneo para realizar experimentos de memoria.
Así, por ejemplo, se libera un pez que, una vez que ha explorado todo el laberinto, pasa gran parte del tiempo en la zona en la que se encuentra más seguro y confortable. Al día siguiente vuelven a introducir el mismo pez en el laberinto: si se dirige directa y rápidamente hacia el lugar del laberinto donde se encontraba a gusto, ello quiere decir que recuerda aquel rincón. Así se obtiene una primera medida de memoria.
Si a ese pez se le eliminan las neuronas colinérgicas, al entrar nuevamente en el laberinto lo habrá olvidado todo y volverá a explorar el lugar como si nunca hubiera estado allí; en este momento se convierte en un modelo muy bueno para probar la eficacia de la molécula y comprobar si bajo su efecto su memoria mejora o no.

Ejemplo de T-Maze, o laberinto en forma de T.
Todo este trabajo son las llamadas pruebas previas a Fase I: queda un largo trayecto hasta que la molécula pueda ser utilizada en seres humanos. No obstante, es muy probable que termine siendo descartada en otra de las numerosas cribas de este extenso proceso.
Se trata de un camino que arranca coleccionando microorganismos recogidos por todas las partes del mundo y que, finalmente, nos puede acercar a una molécula candidata eficaz contra alguna de las dianas terapéuticas del Alzhéimer.
En definitiva, se busca una diminuta aguja perdida en un inmenso pajar. Con paciencia, trabajo constante, esfuerzo, rigurosidad en todos los pasos y suerte, quizá pueda finalmente encontrarse.



